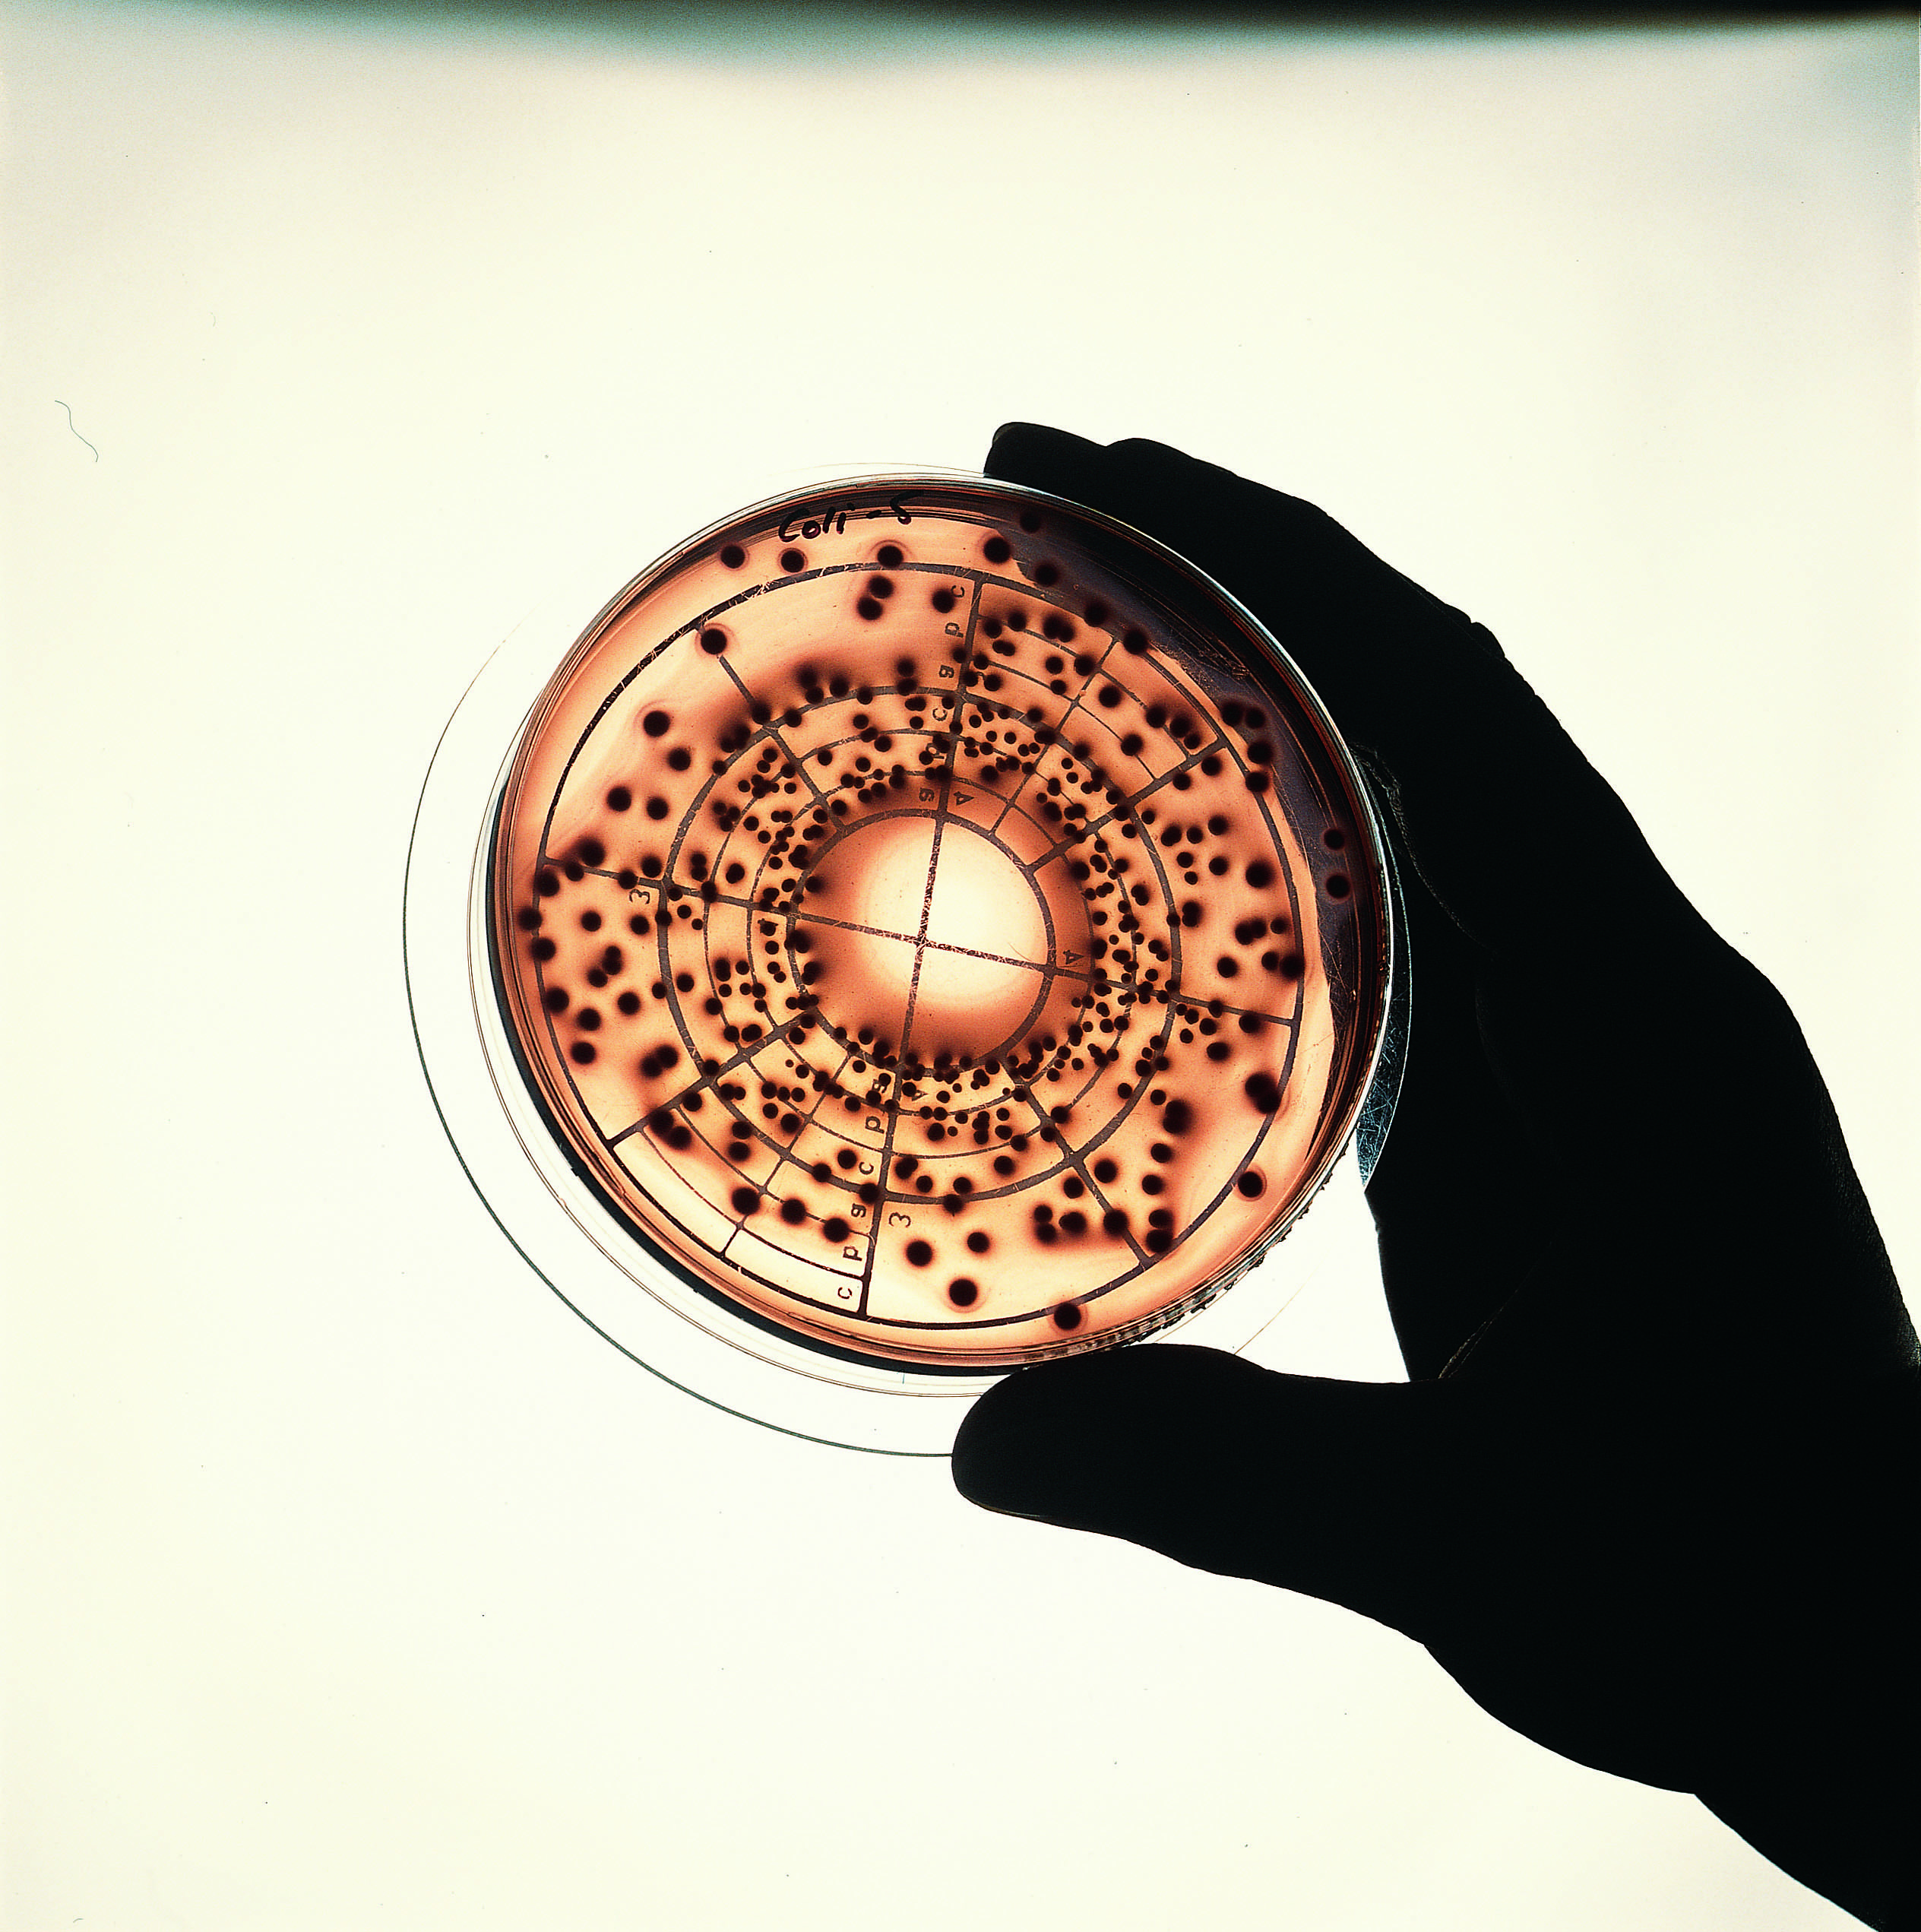

Nous utilisons des cookies pour vous fournir l'ensemble de nos services, notamment la recherche et les alertes. En acceptant, vous consentez à notre utilisation de ces cookies.
Choisir mes préférences

Comprendre les principes et se familiariser avec les bonnes pratiques de la culture cellulaire eucaryote animale. Conduire en autonomie des cultures cellulaires eucaryotes animales.
NOTIONS THÉORIQUES
– Rappels sur les cellules eucaryotes et leurs besoins fondamentaux (nutrition, oxygénation, pH, température, adhérence)
– Bonnes pratiques en culture cellulaire : niveau de biosécurité,
stérilité, PSM, gestion des déchets
– Les différents supports de culture cellulaire
– Les différents types de culture cellulaire :
– Culture primaire ou lignée ?
– Cellules adhérentes ou en suspension ?
– Les milieux de cultures, les sérums et facteurs de croissance
– Décongélation et congélation des cellules
– Le cycle cellulaire et les différentes phases de la prolifération cellulaire
ATELIERS PRATIQUES
– Décongélation et congélation des cellules
– Ensemencement cellulaire
– Comptage cellulaire et suivi de la prolifération
– Identification de cellules en phase S du cycle cellulaire
Ingénieurs, techniciens, doctorants, chercheurs souhaitant comprendre les principes et se familiariser avec les bonnes pratiques afin d’être opérationnel et autonome en culture cellulaire eucaryote animale.
Connaître les bases théoriques de la biologie cellulaire
20 % Enseignements et 80 % Travaux pratiques
Mises en situation, analyse de cas, mises en applications.
Voir plus
Infos
Trouver le bon CACESComprendre l'habilitation éléctriqueMentions légalesConditions d'utilisationNous utilisons des cookies pour vous fournir l'ensemble de nos services, notamment la recherche et les alertes. En acceptant, vous consentez à notre utilisation de ces cookies.
Choisir mes préférences